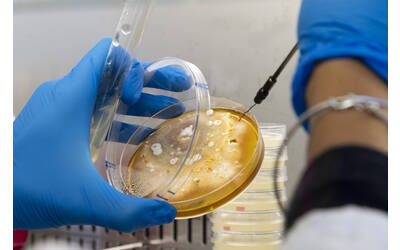

Descrizione
Operativo dal 2004 a supporto del Servizio Fitosanitario Provinciale, attualmente è Laboratorio Ufficiale del medesimo.
Struttura di servizio consolidata, dal 2021 ha ottenuto l’accreditamento ACCREDIA, a garanzia di servizi diagnostici qualificati.
L’analisi diagnostica è svolta per ricercare malattie delle piante causate da batteri, funghi, insetti, acari, nematodi, virus, viroidi e fitoplasmi attraverso tecniche diagnostiche tradizionali (microbiologia, microscopia e sierologia) e tecniche molecolari.
Le principali colture interessate sono vite, melo, piccoli frutti, ciliegio, albicocco, susino, pero, noce, actinidia e piante orticole, ornamentali e forestali.
Virus e viroidi
Dal test immunoenzimatico ELISA a metodi di biologia molecolare (RT-PCR e Real Time RT-PCR) fino al sequenziamento.
Funghi
Dalla camera umida, all’isolamento e identificazione morfologica fino all’analisi di biologia molecolare con amplificazione genica (PCR- Real Time PCR) e sequenziamento.
Batteri
Dall’isolamento e identificazione, all’analisi di biologia molecolare con amplificazione genica (PCR- Real Time PCR) fino al sequenziamento.
Fitoplasmi
Analisi di biologia molecolare con amplificazione genica (PCR- Real Time PCR).
Nematodi
Su campioni di terreno o matrici vegetali mediante estrazione, analisi morfometrica con la possibilità di confermare o approfondire mediante amplificazione genica e sequenziamento.
Acari e insetti
Analisi morfometrica e molecolare mediante amplificazione genica, sequenziamento e DNA barcoding.
Oltre ai saggi elencati il laboratorio offre all’occorrenza la possibilità di implementare analisi su patogeni e colture diverse da quelle indicate.